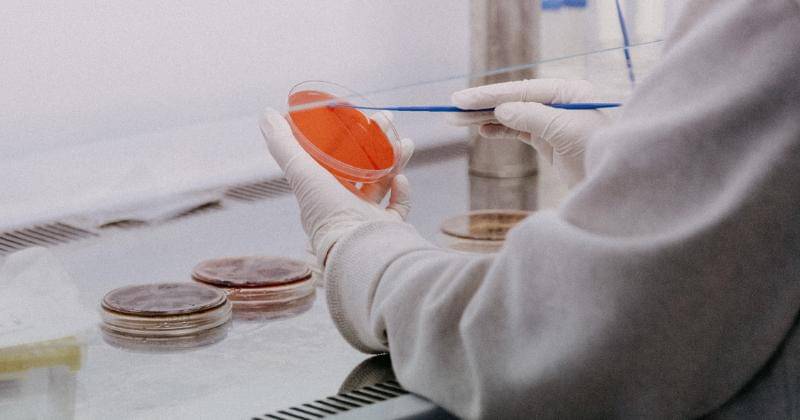
Unsplash/trnavskauni

China Lakukan Tes Swab Lubang Anus, Metode Baru Cegah Covid-19

Lonjakan kasus Covid-19 yang ada di China membuat pemerintah setempat semakin memperketat dengan melakukan rangkaian tes.
Hal ini juga dilakukan karena sebentar lagi negara China akan memperingati Tahun Baru Imlek. Seperti yang kita tahu China menjadi negara pertama yang mendeteksi adanya virus Covid-19 dan hingga sekarang masih bergelut dengan virus tersebut.
Untuk memperketat negaranya, pemerintah China memperkenalkan cara swab terbaru yang dilakukan melalui lubang anus.
Ini merupakan cara terbaru untuk memperketat China dari lonjakan kasus Covid-19. Popmama.com sudah merangkum beberapa informasi dari berbagai sumber:
1. Swab melalui lubang anus dilakukan bagi pendatang dari luar negeri
Pemerintah China sangat memperketat pendatang dengan berbagai tes yang harus dilakukan ketika sampai di China. Setidaknya para pendatang harus melakukan empat macam tes yaitu tes darah, swab hidung, swab tenggorokan dan swab melalui lubang anus.
Swab melalui lubang anus dilakukan kepada para pendatang luar negeri di hari ke 12 karantina mereka. Dikutip dari Kompas.com, salah satu mahasiswa yang baru saja kembali dari Korea Selatan dan melakukan 14 masa karantina di hotel. "Rasanya sangat malu. Tidak ada perasaan lain. Selamat menjalani," tulis Douyacai pada salah satu postingan di akun media sosialnya.
Beberapa orang yang telah melakukan swab lubung anus juga mengiyakan perasaan malu dalam melakukan hal ini tetapi mereka sadar bahwa ini dilakukan untuk kebaikan bersama.
2. Pengawasan tetap dilakukan oleh pemerintah untuk pendatang dari luar negeri

Selain melakukan serangkaian empat tes, para pendatang juga diwajibkan untuk melakukan karantina selama 14 hari dan juga 14 hari isolasi mandiri setelah selesai masa karantina.
Di beberapa wilayah menerapkan masa karantina dan isolasi mandiri yang berbeda sesuai dengan status wilayah tersebut.
3. Menurut pakar, swab hidung dan tenggorokan masih paling efektif untuk deteksi Covid-19

Salah satu pakar kesehatan dari Universitas Wuhan, Dr Yang Zhanqiu, menyatakan bahwa swab hidung dan tenggorokan adalah tes yang paling efisien untuk mendeteksi Covid-19, dikarenakan asal menularnya virus ini melalui saluran pernapasan.
Beliau juga menyatakan beberapa kasus positif Covid 19 juga ditemukan dari kotoran pasien tetapi tidak ada bukti yang menunjukan bahwa penularan terjadi melalui sistem pencernaan.
4. Swab melalui lubang anus baik dilakukan untuk evaluasi pasien yang akan keluar RS

Hasil penelitian yang dilakukan oleh beberapa peneliti China dalam makalahnya menyimpulkan bahwa swab melalui lubang anus atau swab anal dapat dilakukan bagi para pasien yang dirawat di RS dan akan pulang.
Jika ditemukan virus di dalam feses, pasien memerlukan adanya isolasi lebih lanjut hingga virus benar-benar tidak ditemukan lagi.
5. Pemerintah China larang warganya mudik untuk merayakan Imlek

Salah satu upaya pemerintah China untuk menekan angka kasus Covid-19 adalah dengan melarang rakyatnya untuk mudik dalam rangka Tahun Baru Imlek 2021. Pada tahun 2019 sebanyak 3 miliar perjalan dilakukan oleh warga dalam periode Imlek.
Dikhawatirkan dengan adanya mudik akan memperbanyak kasus yang terjadi di negara tersebut. Beberapa hal yang dilakukan pemerintah dalam melarang mudik warganya seperti di Beijing, pemerintah daerah melarang adanya pertemuan massal, perayaan tahun baru Imlek di tempat ibadah dan juga kegiatan olahraga.
Bagi mereka yang akan melakukan perjalanan harus melakukan tes swab dan menunjukan hasil tes Covid-19 negatif yang dilakukan 7 hari sebelum perjalanan.
Dalam dua minggu terakhir ini, pemerintah China berhasil menunjukan tingkat terendah dalam kasus Covid-19. Dengan adanya larangan dan rangkaian tes yang dilakukan, pemerintah setempat berharap dapat menekan angka kasus ini.
Sejak 26 Januari, Komisi Kesehatan Nasional China melaporkan terdapat 75 kasus baru. Dari kasus tersebut 50 kasus merupakan kasus lokal dan 20 kasus penularan impor.
Itulah informasi mengenai swab melalui lubang anus, membayangkannya saja nyilu ya, Ma.



















